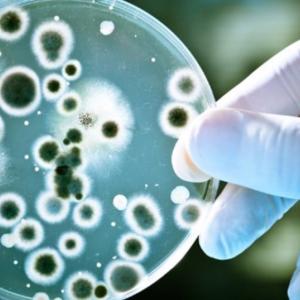

蒙央行共收购17.8吨贵金属
经济
蒙通社乌兰巴托2月2日电,2023年12月,蒙央行共收购1,795.8公斤贵金属。较年初,共收购17.86吨贵金属。蒙央行达尔汗乌拉省分行共收购1,961.4
公斤贵金属,巴彦洪格尔省分行共收购1,106.9公斤贵金属。
蒙央行收购贵金属价格,根据世界市场价格而定。2023年12月的平均价格为223,029.83
图格里克。
 Улаанбаатар
Улаанбаатар